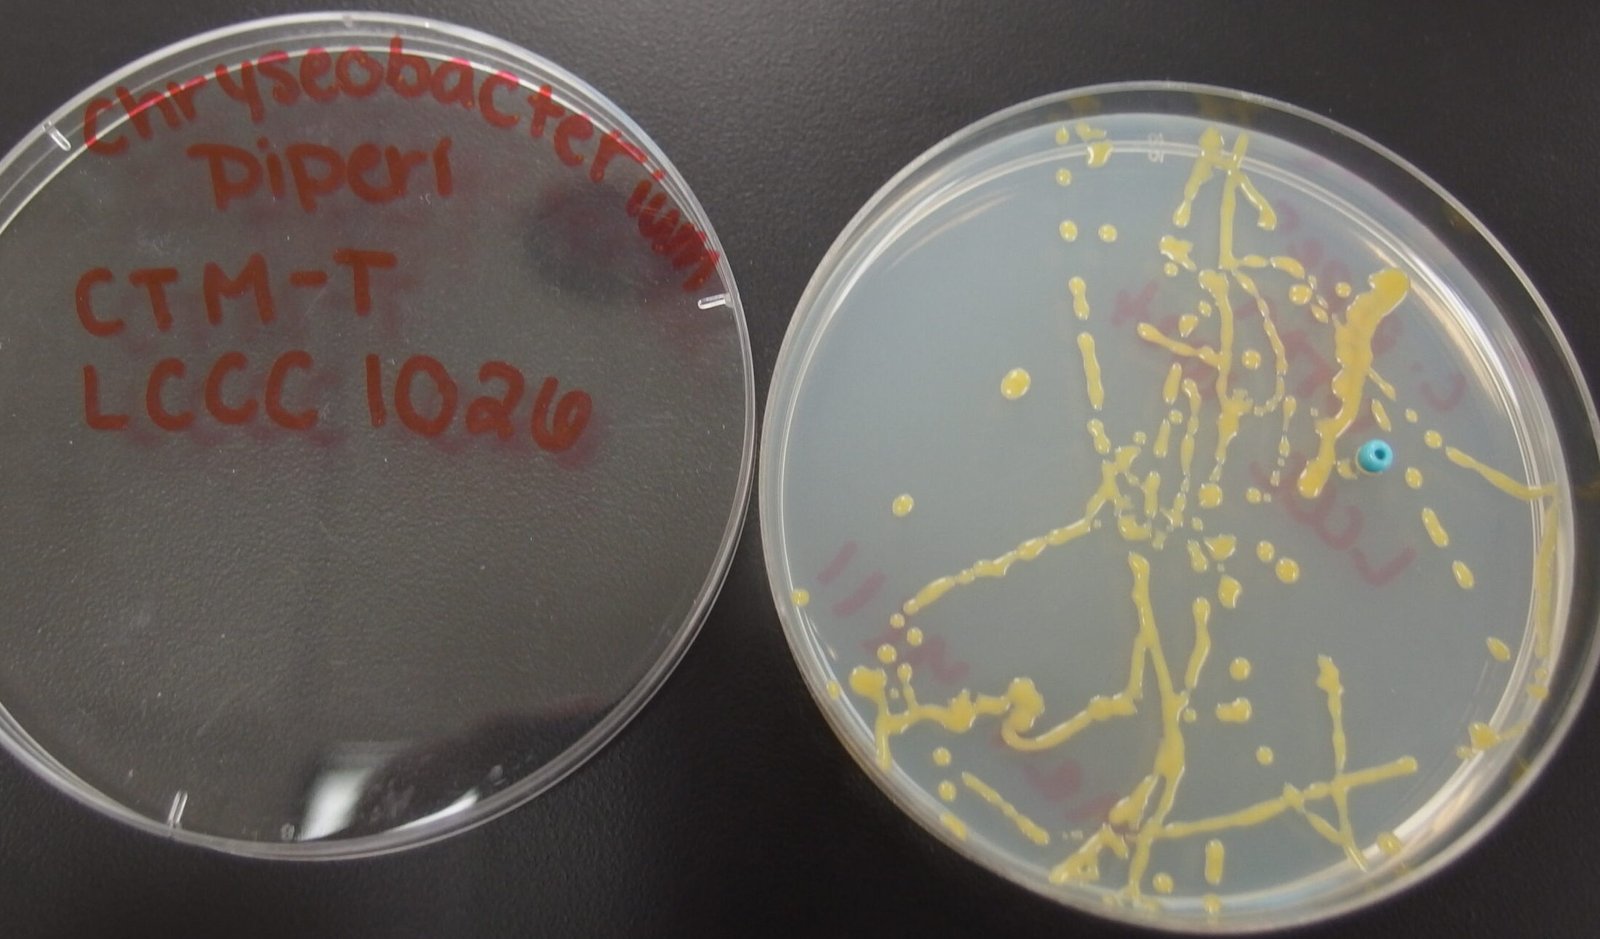

Bacterial Strains Available
We have accumulated over 1000 well characterized bacterial and yeast strains during the past 25 years, with many novel species among them. We will gradually add organisms to the list below with relevant information, initially focusing on those with genome sequence data. Our complete culture collection spreadsheet is available upon request. Standard prices are $75/strain for individuals at non-profit organizations; $150/strain for individuals at for profit institutions; with discounts available for requests of more than 5 strains. We are also open to trade strains as well.
Available Strains
| Genus species | strain | LCCC# | Accessions | BLAST vs Types | BLAST vs core_nt | Phylogeny |
|---|---|---|---|---|---|---|
| Chryseobacterium piperi | CTMT | 1026 | 16S=EU999735, genome=JPRJ01 doi=/10.1099/ijs.0.027805-0 | Type | Type | Bacteroidota; Flavobacteriales; Weeksellaceae |
.
Contact Us Today
Inquiries